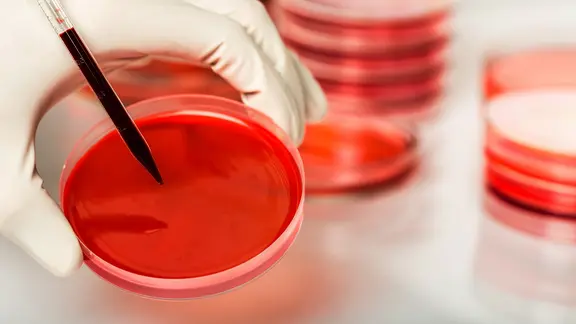
Eine Blutprobe in einer Petrischale im Labor | panthermedia, billiondigital Eine Blutprobe in einer Petrischale im Labor

Stammzellenspende: Ablauf, Risiken und Voraussetzungen | ABC-Z

Stand: 19.09.2025 11:21 Uhr
Die Stammzellenspende erfolgt meist als Blutspende, selten als Knochenmarkspende. Stammzellen zu spenden dauert wenige Stunden. Vor allem bei Blutkrebs (Leukämie) wird Stammzelltransplantation genutzt.
Stammzellenspende oder Stammzelltransplantation ist bei schweren Blutkrankheiten oft die einzige Chance zu überleben. Aus transplantierten Stammzellen soll sich im Körper der Patienten ein neues blutbildendes System entwickeln.
Wie läuft eine Stammzellenspende ab?
Erste Voraussetzung für eine Stammzellspende ist ein “perfektes Match” von Spenderin oder Spender, die in einer (weltweiten) Spenderdatei erfasst sind – beispielsweise durch DKMS-Typisierung oder beim Zentralen Knochenmarkspender-Register Deutschland, ZKRD. Passen die eigenen Gewebemerkmale genau zu denen eines Patienten, wird man kontaktiert. Spender oder Spenderin werden zur Blutprobe gebeten, untersucht und zu Ablauf und Risiken der Stammzellenspende gibt es Aufklärungsgespräche. Dann kann es entweder Tage, Wochen oder auch Monate dauern, ehe es zur Spende kommt.
Stammzellenspende: Ablauf in zwei Verfahren
Die Entnahme der Stammzellen erfolgt grundsätzlich auf zwei unterschiedliche Arten:
- 1. Spende von Blutstammzellen: Die periphere Stammzellspende funktioniert über direkte Entnahme der Stammzellen aus der Blutbahn. Diese Form der Stammzellenspende kommt bei 90 Prozent der Spenden zur Anwendung.
- 2. Stammzellenspende aus Knochenmark: Bei dieser Art der Stammzellenspende werden Stammzellen im Rahmen einer OP aus dem Knochenmark des Beckenknochens gewonnen. Die Knochenmarkspende erfolgt nur bei zehn Prozent der Spenden. Mit welcher Methode die Stammzellen vom Spender oder der Spenderin gewonnen werden, ist eine ärztliche Entscheidung. Dabei werden die Bedürfnisse der Patienten, aber auch die Wünsche der spendenden Person berücksichtigt.
So funktioniert die periphere Stammzellenspende (Blutstammzellen)
Spender oder Spenderin bekommen etwa fünf Tage vor der Spende ein Medikament gespritzt, das die Produktion von Stammzellen erhöht und sie verstärkt ins Blut schwemmt. Wirkstoff ist dabei der hormonähnliche, körpereigene Wachstumsfaktor G-CSF (Granulocyte-Colony Stimulating Factor).
Die Entnahme der Stammzellen erfolgt ambulant im zertifizierten Entnahmezentrum. Der Ablauf folgt dem Prinzip der Blutwäsche (Apherese): Dem Spender werden zwei Zugänge an den Armvenen gelegt. Durch den ersten Zugang fließt das Blut aus dem Körper in eine Maschine. Dort werden Stammzellen vom Blut getrennt und gefiltert. Über den zweiten Zugang wird das Blut zurück in den Körper geleitet.
Diese Form der Stammzellspende erfolgt ohne Narkose und dauert drei bis fünf Stunden. Danach geht der Spender nach Hause. Um ausreichend Stammzellen aus dem Blut zu erhalten, kann es nötig sein, die Spende am nächsten Tag zu wiederholen.
So funktioniert die Knochenmarkspende
Die Knochenmarkentnahme dauert etwa eine Stunde und erfolgt per OP unter Vollnarkose in einer Entnahmeklinik. Eine Punktionsnadel wird zum Beckenkamm (Rand des größten Knochens im Becken) geführt. An diesem Rand des Beckenknochens ist das Knochenmark nur durch eine dünne Knochenschicht von der Haut getrennt und kann darum gut entnommen werden. An mehreren Stellen wird der Beckenkamm punktiert: 500 bis maximal 1.500 Milliliter eines Gemischs aus Knochenmark und Blut werden abgesaugt. Das entspricht in etwa fünf Prozent des Gesamtknochenmarks.
Beim Spender bildet sich das Knochenmark innerhalb weniger Wochen nach. Das Rückenmark im Wirbelkanal bleibt unangetastet. Nach der “Stammzellenspende per Knochenmarkspende” braucht es üblicherweise einen Krankenhausaufenthalt von ein bis zwei Nächten. Anschließend sollten sich Spendende einige Tage zu Hause erholen.
Wie schmerzhaft ist eine Stammzellenspende?
Bei einer Stammzellenspende per Blutspende kann das vorbereitende Medikament mit dem Wachstumsfaktor G-CSF müde machen oder grippeähnliche Symptome wie Fieber, Kopfschmerzen, Muskelschmerzen oder Gliederschmerzen auslösen. Dagegen helfen Schmerzmittel. Die periphere Stammzellenspende selbst ist nicht schmerzhaft. Lediglich der Einstich der Nadeln zum Legen der Zugänge kann kurz schmerzen.
Die Knochenmarkspende erfolgt unter Vollnarkose; Spender haben also keine Schmerzen bei der Spende. Nach einer Knochenmarksspende ist aber die Einstichstelle ein paar Tage druckempfindlich. Es können Wundschmerz sowie Blutergüsse auftreten. Nach der Spende sollte man auf schwere körperliche Anstrengung verzichten.
Risiken und Langzeitfolgen: Ist Stammzellenspende gefährlich?
Die Wahrscheinlichkeit von Komplikationen durch Stammzellenspende ist bei Gesunden gering. Eine mögliche Nebenwirkung des Wachstumsfaktors G-CSF ist die vorübergehende Vergrößerung der Milz. Um einer Überdehnung der Milz vorzubeugen, sollten Spender während der Einnahme bis sechs Tage nach der Spende keine schwere körperliche Arbeit, Kraftsport sowie Kontaktsportarten machen. Unmittelbar nach einer Knochenmarkspende kann die körperliche Leistungsfähigkeit eingeschränkt sein. Außerdem birgt die Entnahme des Knochenmarks Risiken durch die OP, wie bei jedem chirurgischen Eingriff. Selten kommt es zu einer Infektion oder Wundheilungsstörung.
Wie viel Geld bekommt ein Spender für eine Stammzellenspende?
Die Stammzellenspende ist eine freiwillige Leistung, daher gibt es keine Bezahlung. Aber alle damit verbundenen Kosten werden erstattet, ab Typisierung und Registrierung. Kommt es zu einer Spende und entsprechenden Vorbereitungen werden Reisekosten, Unterkunft und Verpflegung bezahlt, in manchen Fällen auch für eine Begleitperson. Außerdem werden in der Regel die Kosten des Verdienstausfalls übernommen.
Wie lange ist man krank nach einer Stammzellenspende?
Für eine periphere Stammzellspende ist kein Krankenhausaufenthalt notwendig. Spender oder Spenderin kann meist schon am nächsten Tag wieder arbeiten. Nach einer Knochenmarkentnahme aus dem Beckenkamm ist man zwei bis drei Tage im Krankenhaus. Daran schließt sich eine Erholungsphase an und man wird meist für drei bis zehn Tage krankgeschrieben.
Spender werden: Registrierung und DKMS-Typisierung
Wer gesund und zwischen 18 und 55 Jahren alt ist, kann sich an einer deutschen Spenderdatei oder Datenbank registrieren lassen, etwa der DKMS. An der Spende Interessierte kriegen in der Regel per Post ein Set mit Formularen und Wattestäbchen für einen Abstrich an der Wange. Nach Rücksendung erfolgt die Typisierung: Gewebemerkmale werden erfasst. Die Daten werden an das international vernetzte ZKRD weitergeleitet.
Die Gewebemerkmale werden mit denen von Patientinnen und Patienten abgeglichen. Es müssen verschiedene Merkmale, sogenannte humane Leukozyten-Antigene (HLA), übereinstimmen. Kommt es zum Match, werden potenzielle Spender kontaktiert, untersucht und zur Stammzellspende geladen. Die Spende ist freiwillig – die Einwilligung zu Registrierung oder Spende selbst kann ohne Angabe von Gründen zurückgezogen werden. Registrierte Personen können in Deutschland bis zum Erreichen des 61. Lebensjahres Stammzellen spenden.
Altersgrenze bei Registrierung: Warum Stammzellenspende nur bis 55?
Die Registrierung bei einer Spenderdatenbank für Stammzellen ist in Deutschland bis zum 55. Lebensjahr möglich, die Spende bis zum 61. Lebensjahr. Danach werden Registrierte aus der Spenderdatei gelöscht. In Österreich ist die Registrierung sogar nur bis zum 35. Lebensjahr möglich. Grund für die Altersbeschränkungen: Mit zunehmendem Alter lassen Qualität und Teilungsrate der Stammzellen nach. Außerdem werden Stammzellen jüngerer Menschen besser angenommen.
Stammzellen: Wer darf nicht spenden?
Ausgeschlossen von der Stammzellspende sind Menschen, die unter einer chronischen oder schweren Erkrankung leiden oder gelitten haben. Außerdem solche, die regelmäßig Medikamente einnehmen. Weitere Ausschlusskriterien sind:
Bei welcher Krankheit braucht man eine Stammzellenspende?
Bei diesen Erkrankungen kann die Stammzellenspende also vor allem helfen:
Können sich Spender und Empfänger kennenlernen?
Beide Seiten – Spendende und Empfangende – bleiben zum Datenschutz sowie Persönlichkeitsschutz zuerst anonym. Drei Monate nach der Spende ist anonyme Kontaktaufnahme via Mail möglich. Ein persönliches Kennenlernen ist in Deutschland erst zwei Jahre nach der Spende erlaubt.